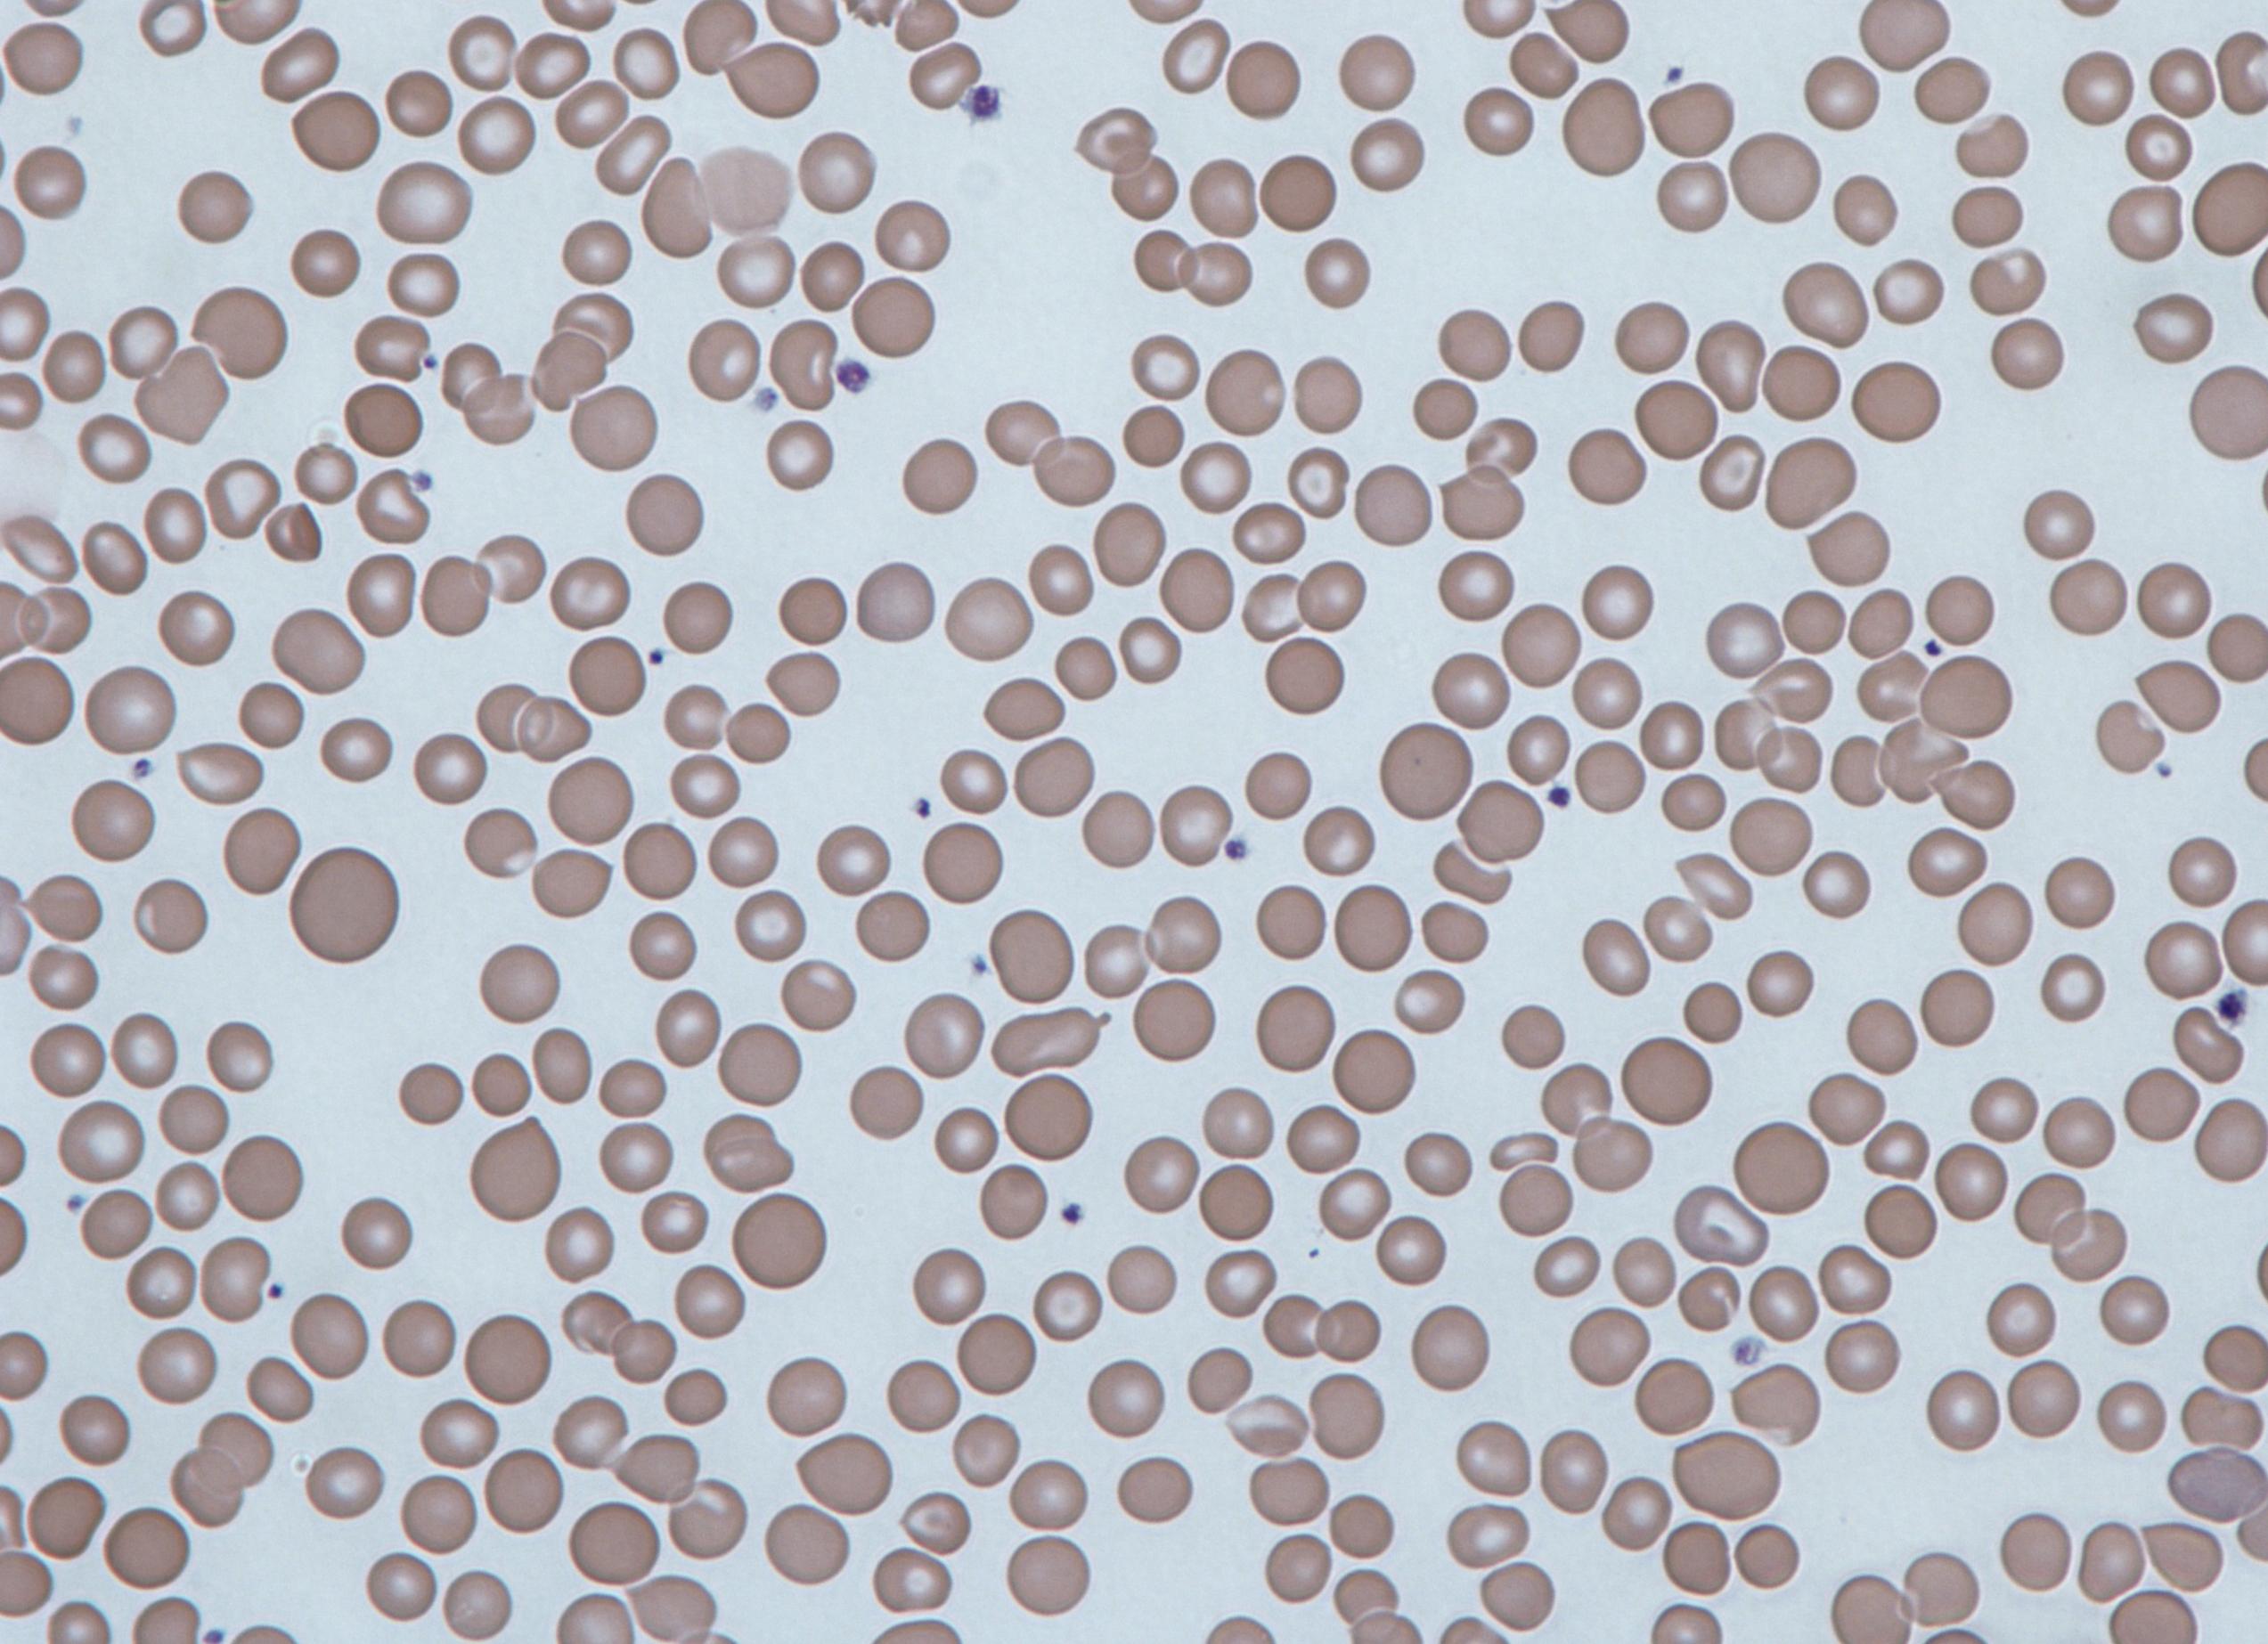
Анизоцитоз эритроцитов что это такое

[Анизоцитоз эритроцитов что это такое]
[Анизоцитоз эритроцитов что это такое]
Анизоцитоз эритроцитов: что это такое, норма, причины повышения и понижения
Для диагностики различных заболеваний большой интерес представляет анизоцитоз эритроцитов.
Часто больные не знают, что это такое, и думают, что врачи обнаружили у них серьезное заболевание, когда слышат про анизоцитоз эритроцитов или тромбоцитов.
Что же представляет собой эта аббревиатура, для чего врачам нужно определять показатели анизоцитоза эритроцитов, и какие нормальные значения он принимает?
Что такое анизоцитоз?
Известно, что красные кровяные тельца выполняют свою особую работу в организме человека.
Основными задачами эритроцитов считается осуществление обмена кислородом между тканями и внутренними органами человека.
При этом диагностический интерес представляет не только изменение общего числа тех или иных типов кровяных телец, но и причины изменения их форм и размеров в данном объеме кровяной сыворотки.
Анизоцитоз эритроцитов – это явление, при котором красные кровяные тельца меняют в сторону увеличения или уменьшения свои размеры и форму.
Принято считать, что в нормальном состоянии для эритроцитов характерен диаметр от 7 до 8 мкм. Взрослые клетки подобного диаметра считаются нормальными и называются нормоцитами.
Маленькие эритроциты диаметром менее 7 мкм называются микроэритроцитами, или микроцитами.
Если же диаметр красных кровяных телец более 8 мкм, то такие клетки считаются макроэритроцитами, или макроцитами.
В случае, когда эритроциты еще больше увеличиваются и достигают размеров свыше 12мкм, их называют мегалоцитами.
Для того чтобы зафиксировать в крови количество измененных по размеру красных кровяных телец, используется показатель анизоцитоза эритроцитов, или RDW.
Он фиксирует то, как распределяются эритроциты по ширине мазка крови. Индекс анизоцитоза эритроцитов измеряется в процентах.
У взрослого здорового человека, вне зависимости от пола и возраста, количество нормоцитов должно составлять не менее 70 % от общего объема эритроцитов в крови.
На долю эритроцитов измененного объема (микроцитов, мегалоцитов и макроцитов) должно приходиться примерно 15 % от всего количества красных кровяных телец.
Изменения показателя анизоцитоза эритроцитов могут иметь исключительно физиологические причины.
Например, у грудных детей до 6 месяцев RDW составляет от 15 % до 19 %. После этого возраста у здорового ребенка отмечается постепенное увеличение в крови количества нормоцитов до тех пор, пока индекс анизоцитоза не станет таким же, как у взрослого человека.
Несколько превышен RDW и у женщин, ждущих малыша, поскольку для состояния беременности характерен дефицит нормоцитов в крови.
Показатель анизоцитоза у беременных женщин может колебаться между 14 % и 16 %. Это состояние не требует особых терапевтических мер, и RDW нормализуется здоровым образом жизни и приемом витаминных и минеральных комплексов с повышенным содержанием железа.
Причины микро- и макроцитозов
Однако зачастую наличие анизоцитоза эритроцитов свидетельствует о каких-либо заболеваниях.
При этом показатели делятся по степени процентного соотношения числа клеток с измененным диаметром в данном объеме крови.
Анизоцитоз бывает:
- первой степени, в случае если число микро- и макроэритроцитов в крови составляет от 30 % до 50 % от общего количества красных клеток. В расшифровке анализов его могут обозначать знаком «+». Такой тип анизоцитоза считается незначительным;
- второй степени, когда число клеток увеличенного и (или) уменьшенного диаметра составляет от 50 % до 70 % от всего числа эритроцитов. Обозначается знаком «++» и считается умеренным анизоцитозом;
- третьей степени, в случае если измененные клетки занимают более 70 % от общего объема. Этот тип анизоцитоза эритроцитов считается выраженным и обозначается «+++»;
- четвертой степени, когда нормоцитов в крови практически нет, и весь объем крови занимают микро-и макроэритроциты. Такое состояние считают резко выраженным.
При этом в зависимости от того, клетки какого размера преобладают в крови, анизоцитоз делят на следующие типы:
- микроцитоз (преобладание микроэрицтроцитов в крови);
- макроцитоз (высокое содержание макроэритроцитов);
- анизоцитоз по смешанному типу (в крови много и больших, и маленьких красных кровяных телец).
Причинами возникновения микроцитоза могут быть следующие патологии:
- наследственные заболевания, при которых нарушается синтез эритроцитов в костном мозгу;
- общее снижение количества и размеров эритроцитов вследствие дефицита железа в организме;
- интоксикация свинцом или другими ядами;
- дефицит витаминов A и B₁₂;
- состояние после большой кровопотери или переливания крови;
- развитие злокачественных новообразований;
- гипохромная сидеробластная анемия;
- нарушения питания.
Макроцитоз обычно наблюдается у младенцев в первые дни жизни, после чего примерно к двум месяцам количество больших клеток в крови ребенка уменьшается, и RDW у него приходит в норму.
Видео:
У взрослых людей анизоцитоз по типу макроцитоза может наблюдаться в результате следующих патологических состояний:
- недостаточной функциональности щитовидной железы, из-за чего мембраны липидов эритроцитов разрастаются;
- гепатоза печени, в том числе стеатоза;
- алкогольной зависимости;
- миелодиспластического синдрома;
- лейкоза эритроцитов;
- недостатка в организме кобаламина и фолиевой кислоты;
- химиотерапии отдельными препаратами;
- микросфероцитоза;
- ишемических болезней;
- синдрома Альцгеймера.
В случае смешанного анизоцитоза, когда в крови много и микро-, и макроэритроцитов, причинами такого состояния могут быть как вышеперечисленные болезни, так и состояние организма в остром периоде хронических заболеваний и после перенесенных вирусных и бактериальных инфекций.
Лечение и профилактика
Изменение размеров эритроцитов считается маркером анемий разного рода. По индексу RDW определяется тяжесть таких патологий.
Однако при проведении курса лечения от железодефицитной анемии, как правило, показатель RDW всегда увеличивается.
В этот период ткани костного мозга начинают вырабатывать клетки большого размера, что приводит к макроцитозу.
После проведенной терапии размеры эритроцитов становятся нормальными, и показатель RDW стабилизируется.
Врачебный интерес представляет высокий RDW. Если при расшифровке ОАК обнаружено, что этот показатель снижен, то придется сдавать кровь заново, потому что, скорее всего, произошла какая-то ошибка при расшифровке диагностических данных.
Для подсчета RDW используют гистограмму распределения эритроцитов, так называемую кривую Прайса-Джонса.
При этом образец крови на предметном стекле помещают под микроскоп и измеряют размеры примерно ста эритроцитов.
Вручную считать индекс анизоцитоза очень трудно, потому что приходится учитывать процентное содержание и макро-, и микро-, и нормоцитов в данном объеме крови, а также строить соответствующий график, что часто приводит к большим погрешностям в вычислениях.
Большим подспорьем для врачей-гематологов стали автоматические анализаторы крови, которые сразу выстраивают изображение кривой анизоцитоза и дают точную и полноценную картину изменения размеров красных кровяных телец.
Анализ крови на анизоцитоз сдают утром на голодный желудок. Взрослые могут выпить стакан воды, для маленьких детей запрет на еду смягчен, однако для уменьшения вероятности неточности расшифровки нужно постараться не кормить ребенка в течение хотя бы двух часов перед забором крови.
Желательно перед сдачей крови не нервничать и не допускать сильных физических нагрузок. Кровь на анизоцитоз берется из пальца.
В случае если в крови обнаружился выраженный или ярко выраженный анизоцитоз, то не стоит нервничать, бросаться в панику и искать причины такого состояния.
Расшифровывать результаты анализов должен квалифицированный специалист-гематолог с учетом остальных данных, жалоб пациента на свое состояние и истории его болезни.
Параллельно с RDW врач оценивает и средний объем эритроцитов в крови.
Бывает и обратная ситуация, когда индекс RDW в норме, однако у человека наблюдаются следующие заболевания:
- болезнь Минковского-Шоффара, при которой эритроциты, не изменяя своего размера, приобретают форму шара;
- анемия, как следствие хронических аутоиммунных процессов;
- наследственные гемоглобинопатии.
Исходя из вышеизложенного, понятно, что анизоцитоз – это не отдельная болезнь, а изменение размеров эритроцитов, которое может иметь, как чисто физиологические причины, так и быть следствием серьезных заболеваний.
Поэтому терапия должна быть направлена, прежде всего, на причину дестабилизации размеров красных кровяных телец.
Если причинами анизоцитоза были не тяжелые заболевания, а неправильный образ жизни, гиперменорея, дефицит в организме витаминов и минеральных веществ, терапия некоторыми препаратами, то врач обычно предписывает следующие меры для нормализации RDW в крови пациента:
- здоровое питание, в котором много продуктов красного цвета – говядины, гранатов, яблок, томатов;
- соблюдение правильного режима сна и отдыха;
- прием поливитаминных комплексов, содержащих железо и витамины A, B₁₂.
Людям, у которых при сдаче анализов каждый раз наблюдается повышение RDW, необходимо наблюдаться у врача гематолога постоянно.
Анизоцитоз эритроцитов норма
Если показатель анизоцитоза эритроцитов выше нормы, то чаще всего это говорит о наличии серьёзных патологических процессов. Анизоцитоз эритроцитов – это разница в размерах между эритроцитами.
Оглавление:
Они могут быть разного диаметра. В бланке анализа крови данный показатель обозначен аббревиатурой RDW (ширина распределения эритроцитов). Данный индекс показывает разницу эритроцитов в объёмах. Если есть заметные повышения или понижения индекса, следует повторно провести исследование для подтверждения диагноза.
Что такое анизоцитоз?
Кровь необходима для нормальной жизнедеятельности человеческого организма. В ней присутствуют форменные элементы, с помощью которых она выполняет свои функции. Кровь переносит кислород и необходимые вещества к органам, поэтому любые патологические изменения нарушают эти процессы.
Исследуемый показатель определяется при исследовании крови. Он демонстрирует нахождение в крови эритроцитов разных размеров.
Состав крови показывает не только явные патологические процессы, но и протекающие латентно. Анизоцитоз эритроцитов отражает увеличение кровяных клеток в размере. Наличие данного показателя (если АЭ повышен) предполагает проведение дополнительного исследования в лаборатории, так как он обнаруживает присутствие серьёзного патологического процесса в организме.
По объёму клетки делятся на следующие группы:
- Нормоциты (7-9 мкм).
- Микроциты (до 7 мкм).
- Макроциты (до 8 мкм).
- Мегалоциты (более 12 мкм).
Кровь содержит в своём составе все виды клеток: от микроцитов до мегалоцитов. Патологией будет являться нарушенное процентное соотношение между ними. Обычно преобладание клеток большего диаметра говорит о патологическом процессе. Большую часть объёма крови занимают нормоциты. Их содержание варьируется в пределах до 85 % от всего количества клеток, остальную часть составляют микроциты и макроциты.
Анизоцитоз эритроцитов чаще всего разделяют на три стадии:
- микроциты и макроциты охватывают не более половины объёма эритроцитов;
- эритроциты, изменившие диаметр, достигают отметки 70 %;
- если эритроциты, увеличившиеся в размерах, достигают показателя более 70 %, то состояние является патологическим.
Такая иерархия позволяет установить тяжесть анизоцитоза. В зависимости от этого врач назначает необходимый курс лечения.
Причины анизоцитоза и расшифровка анализа
- Железодефицитной анемии.
- Гемотрансфузии.
- Дефицита витамина В12.
- Нарушения выработки костным мозгом форменных элементов крови.
- Онкологии.
- Заболеваний печени.
- Анемий различных видов.
- При нарушении деятельности щитовидной железы.
Следует знать, что у новорождённых изменение объёма красных кровяных клеток не говорит о проявлении какой-либо патологии.
На RDW могут влиять такие заболевания, как лейкоцитоз или ретикулоцитоз. Более глубокое исследование (мазок) позволяет установить точные размеры красных кровяных телец. Однако нельзя говорить о наличии заболевания при одном лишь анизоцитозе. Показатель может быть нормальным при талассемии или, к примеру, быть повышенным во время вынашивания ребёнка, а также у новорождённых детей.
Диагностика и лечение
Снижение показателя RDW обычно говорит о таких заболеваниях, как лейкемия и вирусные инфекции различного рода, лучевая болезнь и хронический гепатит, цирроз печени и другие.
Симптоматика при анизоцитозе обычно следующая:
- быстрое утомление;
- беспричинное учащённое сердцебиение;
- появление одышки;
- бледность кожных покровов, ногтей.
При появлении данных симптомов следует как можно быстрее обратиться к врачу.
При данном заболевании следует скорректировать режим питания. Также специалист должен назначить препараты, позволяющие повысить уровень гемоглобина. При анемии врач обычно назначает диету, которая восполняет дефицит железа в крови. В неё входят такие продукты, как гречневая крупа и мясо, печень и другие. Выраженная анемия требует срочного назначения лекарственных препаратов.
При опухолевом процессе необходимо применить лечение методом химиотерапии либо произвести хирургическое вмешательство. Иногда анизоцитоз выражен лишь в небольшой период времени: в такой ситуации лечение обычно не требуется.
Анизоцитоз является лишь признаком какого-то заболевания. Появление данного показателя при исследовании крови говорит о том, что в организме не всё гладко. Курс лечения должен быть направлен на устранение причины появления анизоцитоза. Необходимо вовремя начать лечение, чтобы избежать возможных осложнений.
Анизоцитоз эритроцитов в анализе крови (индекс RDW)
Анизоцитозом эритроцитов называют изменение размеров красных кровяных клеток. Эритроциты могут иметь разные диаметры. Зрелые клетки с диаметром 7-8 мкм являются нормальными и называются нормоцитами. У микроцитов диаметр составляет менее 7 мкм, у макроцитов – от 8 мкм, у мегацитов – от 12 мкм. Показатель анизоцитоза эритроцитов обозначается в анализе крови как RDW. Этот эритроцитарный индекс называют показателем гетерогенности красных клеток по объему. Расшифровывается аббревиатура как ширина распределения эритроцитов.
Норма RDW
У здоровых людей количество нормальных эритроцитов в анализе крови составляет не менее 70 %, макроцитов и микроцитов – не более 15 %. Для взрослых мужчин и женщин этот показатель должен находиться в диапазоне от 11,5 до 14,5 %.
У детей младше шести месяцев индекс RDW должен составлять от 14,9 до 18,7 %. Начиная с шести месяцев, этот параметр по значению приближается к норме взрослого человека – 11,6-14,8 %.
Классификация анизоцитоза
Выделяют четыре степени:
- первая (незначительный анизоцитоз) – микроциты и макроциты составляют%;
- вторая (умеренный) –%;
- третья (выраженный) – выше 70 %;
- четвертая (резко выраженный) – практически все красные клетки имеют размер, отличный от нормального значения.
В зависимости от увеличения количества тех или иных форм эритроцитов, различают:
- микроцитоз – увеличение числа малых клеток;
- макроцитоз – увеличение числа макроцитов;
- смешанный – увеличение числа и малых, и больших клеток.
Микроцитоз обычно наблюдается при следующих состояниях:
- анемии железодефицитной;
- при отравлении свинцом;
- талассемии;
- сидеробластной анемии;
- при анемии, связанной с хроническими кровотечениями;
- при некоторых злокачественных заболеваниях.
При анизоцитозе в крови присутствуют эритроциты как малых, так и больших размеров
Макроцитоз может являться вариантом нормы или быть патологическим. В первом случае речь идет об анизоцитозе новорожденных в первые две недели жизни, к двум месяцам состояние нормализуется. Патологический макроцитоз обусловлен следующими причинами:
- нарушением синтеза ДНК, который может быть связан с приемом некоторых медикаментов, миелодисплазией, эритролейкозом, дефицитом фолиевой кислоты и кобаламина.
- патологией липидов мембраны эритроцитов при заболеваниях печени, алкоголизме, гипотериозе, после удаления селезенки.
При смешанном анизоцитозе могут преобладать как микроциты, так и макроциты. В первом случае, как правило, имеет место гипохромная анемия. Если преобладают макроциты, то не исключена возможность B12-дефицитной или пернициозной анемии.
Причины повышения и понижения RDW
Анизоцитоз – это ранний признак анемий, тяжесть которых определяется его степенью. Основные причины повышения RDW как у взрослых, так и у детей следующие:
- Железодефицитная анемия.
- Гемолитическая анемия.
- Мегалобластная анемия (дефицит витамина B12 и фолиевой кислоты).
- Хронические болезни печени.
- Метастазы в печень.
- Переливания крови.
- Миелодиспластический синдром.
- Алкогольная зависимость.
Крое этого, RDW может быть повышен при болезни Альцгеймера, гемоглобинопатии, отравлении свинцом, микросфероцитозе, метаплазии костно-мозговой, при сердечно-сосудистых заболеваниях.
Во время лечения анемии железодефицитной индекс анизодизода повышается. Это объясняется появлением в крови большого количества молодых эритроцитов, которые отличаются по диаметру от зрелых. При эффективном лечении RWD нормализуется, но после остальных индексов.
Изменение размера эритроцитов по диаметру считается диагностическим маркером, информирующим о риске развития ишемической болезни сердца.
При некоторых патологиях изменения RDW не происходит, показатель остается в норме. Сюда относятся следующие состояния:
- малокровие, сопровождающее хронические заболевания;
- β-талассемия;
- сфероцитоз;
- острые апластические и геморрагические анемии;
- серповидно-клеточная анемия.
Анализ на RDW
Кровь на анизоцитоз исследуют во время общего анализа. Забор производится из пальца. Сдавать нужно натощак в утренние часы. Степень анизоцитоза может определяться лаборантами вручную. Сегодня все чаще индекс RDW подсчитывается на современных гематологических анализаторах, дающих быстрый и более точный результат. Данный параметр определяется автоматически по специальной формуле с учетом других эритроцитарных индексов.
Расшифровка анализа проводится лечащим врачом, при этом учитываются значения других показателей. Так, параллельно с оценкой RDW оценивают эритроцитарный индекс MCV (средний объем эритроцитов). Это связано с тем, что индекс анидоцитоза может оставаться в норме, но наличие микро- и макроцитов при этом является патологией.
Значение индекса анизоцитоза необходимо врачу, чтобы интерпретировать результат анализа, проводить диагностику анемий, в том числе дифференциальную. Определение количества эритроцитов в крови и уровня гемоглобина не дает полной картины, а свидетельствуют лишь о наличии малокровия.
Заключение
Если индекс RDW в анализе крови выше нормы, это может свидетельствовать о развитии анемии. Такие изменения в данном случае являются ранним диагностическим признаком. По одному показателю крови, такому как анизоцитоз, невозможно судить о состоянии здоровья, поскольку при ряде заболеваний, в том числе при талассемии, RDW может оставаться в норме. Данный индекс используется в медицине как вспомогательный критерий при диагностике анемий. При этом необходимо рассматривать и другие эритроцитарные индексы.
Анизоцитоз — это патологическое состояние, при котором происходит изменение размеров эритроцитов. Анизоцитоз в общем анализе крови
Анизоцитоз — это такое нарушение в организме, когда красные кровяные клетки изменяют свои размеры. У эритроцитов может быть разный диаметр. Более подробно этот вопрос рассмотрим в данной статье.
В анализах показатель обозначается следующими буквами RDW. Это эритроцитарный индекс, который принято называть показателем неоднородности красных клеток в объеме. Если расшифровать данную аббревиатуру, то она означает ширину распределения эритроцитов. Анизоцитоз говорит о развитии в организме какой-либо патологии.
Изменение размеров эритроцитов и тромбоцитов
На самом деле врачи при определении состояния здоровья человека опираются не только на количественный состав крови. После общего анализа появляется представление о происходящих в организме изменениях, по размеру и виду эритроцитов, тромбоцитов. Анизоцитоз — это довольно необычные нарушения, которые возникают у взрослых и детей и могут привести к патологиям, связанным с изменением размеров кровяных клеток, что может указывать на развитие заболеваний и делает необходимым проведение дополнительных обследований и лечения.
Отличительные признаки заболевания
Как выявить анизоцитоз в общем анализе крови? У человека она содержит тромбоциты, которые отвечают за ее свертывание, лейкоциты. Их называют белыми тельцами, которые выполняют свои функции в борьбе с чужеродными частицами и инфекциями. Очень важную роль для жизнедеятельности играют эритроциты, которые транспортируют кислород и питательные вещества к клеткам и занимаются переносом углекислого газа. Строение и форма эритроцитов неодинакова, то есть они представлены разными размерами:
- К нормоцитам относятся клетки размером от семи до девяти микрометров.
- Микроциты или микроэритроциты – это клетки размером до семи микрометров.
- К макроцитам можно отнести клетки величиной от восьми микрометров.
- Мегалоциты — это клетки размером от двенадцати микрометров.
При условии, что все показатели эритроцитов в крови в норме и человек полностью здоров, количество нормоцитов не превышает семьдесят процентов от общего числа эритроцитов, а на макроциты и микроциты приходится в сумме до пятнадцати процентов. Если в ходе проведения анализов становится известно, что какой-то показатель выше нормы или, напротив, ниже положенного, это свидетельствует о каких-либо нарушениях в организме. Рост показателя RDW связан с увеличением количества больших и малых клеток. Такие же изменения происходят с тромбоцитами. Если сказать по-другому, у человека появляются изменения, связанные с размером кровяных клеток.
Из определения следует, что анизоцитоз в общем анализе крови — это модификация размеров эритроцитов и тромбоцитов. В случае, когда это нарушение слабо выражено, следует провести ряд дополнительных исследований, чтобы отбросить вероятность серьезных заболеваний организма. Гемоглобин снижается в красных кровяных клетках и это приводит к анемии. Несмотря на это, следует тщательным образом проверять состояние крови для того, чтобы исключить более серьезные отклонения.
Стадии и виды анизоцитоза
Анизоцитоз — это отклонение от нормы, которое можно разделить на степени, согласно его тяжести:
- 1-я степень — незначительный или умеренный, при котором в крови наблюдается тридцать-пятьдесят процентов микроцитов или макроцитов.
- 2-я степень — средняя, в состав эритроцитов на пятьдесят-семьдесят процентов входят микроциты или макроциты.
- 3-я степень — резкая или выраженная, эритроциты состоят более чем на семьдесят процентов из микроцитов или макроцитов.
Анизоцитоз смешанного типа
При смешанном типе изменения размеров клеток крови общее количество макро и микроцитов в крови не поднимается выше 50%. Выявить это поможет кривая Прайса-Джонса. Если говорить о смешанном анизоцитозе, то в крови будут преобладать макроциты. Чаще диагностируют либо пернициозную анемию, либо анемию, вызванную дефицитом витамина В12.
Нормальный показатель RDW — в среднем четырнадцать-восемнадцать процентов. Отклонение от нормы, вызванное уменьшением или увеличением размеров тромбоцитов, может быть слабой и средней тяжести.
Основание развития
Размеры тромбоцитов изменяются по разным причинам. При миелонеопластических процессах наблюдается серьезное повышение диаметра клеток. Размер тромбоцитов уменьшается при синдроме диссеминированного внутрисосудистого свёртывания, апластической анемии, нарушении функций печени, лейкемии и некоторых других болезнях. Так называемый изолированный анизоцитоз эритроцитов присутствует на легких этапах анемии, и может возникать во время месячных, если они затянулись по какой-то причине.
Изменение размеров красных кровяных клеток чаще всего становится одним из симптомов анемии. Нередко такой диагноз ставят детям. Зачастую отклонение отмечают как признак гипохромии, постгеморрагической анемии, хлороза, что указывает на процессы дегенерации в крови. Данный синдром не обладает самостоятельным характером. Другие причины развития анизоцитоза:
- недостаточное количество витамина А;
- нехватка витамина В12 и железа;
- переливание крови.
Анизоцитоз в последнем случае проходит самостоятельно. Организм приспосабливается к так называемой «обновленной» крови, а больные клетки заменяются здоровыми.
Симптомы отклонения
Анизоцитоз — это состояние, которое в большинстве случаев является признаком анемии. Симптомы похожи между собой. Тяжелые признаки такого состояния напоминают проявление сердечной недостаточности. Если Вы обнаружили описанные ниже признаки, обратитесь к врачу и сдайте общий анализ крови:
- быстрая утомляемость;
- понижение работоспособности;
- падение концентрации внимания;
- отсутствие способности заниматься спортом;
- бессилие и упадок сил;
- одышка при нагрузках или без видимых на то причин, появляющаяся периодически;
- частое сердцебиение без каких-либо нагрузок;
- усиление толчков сердечной мышцы;
- бледная кожа;
- бледный цвет ногтевых пластин;
- бледность глазных яблок;
- болит голова;
- шум в ушах;
- нарушения нормального аппетита и сна;
- снижается уровень полового влечения;
- нарушение чувствительности кожи.
При появлении этих симптомов необходимо обратиться к врачу.
Проведение диагностики
Как выявляют анизоцитоз? Норма была указана ранее.
Главный способ диагностики — это анализ крови по всем показателям. В нем указывается характеристика состава крови, показатели эритроцитов и тромбоцитов, необходимые для того, чтобы выявить анизоцитоз. Эритроцитарный индекс можно узнать по строке, которая именуется коэффициентом вариации объема эритроцитов и средним отклонением объема эритроцитов. Для исследования тромбоцитов характерна строка — средний объем тромбоцита и показатель анизоцитоза тромбоцитов.
Способы и методы лечения
Врачи предлагают каждому больному как можно быстрее изменить систему питания и пищевой рацион, в который включаются минералы и витамины. Вредную пищу следует убрать из рациона питания, чтобы организм не тратил свой ресурс на «очищение» от продуктов ее распада.
Без наличия серьезных заболеваний простое изменение питания и образ жизни без вредных привычек, необходимый для организма сон помогут пациенту избавиться от анизоцитоза. Очень часто врачи рекомендуют принимать препараты, содержащие железо и витамин Б12, которые находятся в дефиците в организме.
Анизоцитоз в общем анализе крови
Кровь – это важнейшая составляющая живого организма, она представляет жидкую ткань, состоящую из плазмы и форменных элементов. Под форменными элементами понимаются тромбоциты, эритроциты и лейкоциты. Кровеносная система соединяет и питает все органы. Поэтому очень важно следить за ее состоянием и регулярно сдавать общий анализ крови. Глядя на него, опытный специалист может судить о появлении возможных нарушений в работе организма.
При рассмотрении общего анализа крови обращают внимание на размер, цвет и форму кровяных телец. По отклонению формы клеток от нормального состояния может судить о пойкилоцитозе.
Анизоцитоз в общем анализе крови свидетельствует о том, что размер кровяных частиц отличается от стандартного. Значительное отклонение от нормы без должного лечения может повлечь за собой серьезные заболевания и нарушения.
Чаще всего пойкилоцитоз и анизоцитоз характерны для эритроцитов, однако, изменение размеров тромбоцитов также имеет место.
Анизоцитоз: что это такое?
Нормальный размер эритроцитов, например, составляет 7-9 микрометров. Допускается присутствие в крови небольшого числа (по сравнению с общим количеством) телец нестандартного размера. В среднем, эта величина составляет 30%. То есть считается нормой, если в крови 15% частиц имеют размер, меньший по сравнению со стандартным, а 15% телец имеют больший, чем у них, диаметр. Но в связи с некоторыми изменениями и нарушениями в организме размер кровяных телец может значительно изменяться и становиться сильно неоднородным.
Анизоцитоз в крови – это превышение уровня частиц нестандартного размера в крови.
В зависимости от того, какие форменные элементы крови изменили свой размер, различают анизоцитоз эритроцитов и тромбоцитов. Рассмотрим подробнее каждый из них.
Анизоцитоз эритроцитов
Увидев у себя в анализе крови устрашающую фразу, к примеру «показатель анизоцитоза эритроцитов выше нормы», не спешите паниковать.
Эритроциты, которые еще по-другому называют красными кровяными тельцами, ответственны в нашем организме за передачу питательных веществ к органам, за унос лишнего углекислого газа и за поставку кислорода.
Как уже было сказано выше, нормальный размер эритроцитов – 7-9 микрометров.
Эритроциты, меньшие по диаметру (
Признаки анизоцитоза эритроцитов и методика лечения патолгии
Кровь является жизненно необходимым составляющим любого организма и представляет собой жидкую ткань с содержанием плазмы и форменных элементов. Состояние здоровья удается определить по внешнему виду тромбоцитов, эритроцитов и иных клеток крови. Нередко при изменении их размера диагностируется такое нарушение, как анизоцитоз эритроцитов. Оно может сигнализировать о развитии в организме человека серьезных заболеваний, которые требуют обязательного лечения.
Признаки и причины развития патологии
Анизоцитоз – это изменение размеров эритроцитов в крови человека
Такое патологическое состояние, как анизоцитоз, может развиваться как результат некоторых изменений либо вмешательств в организм:
- дефицит железа в организме человека
- переливание крови
- диагностирование у пациента онкологических патологий
- недостаточное поступление в организм витамина А и В 12
- развитие у больного миелодиспластического синдрома
В том случае, если в организм человека поступает недостаточное количество железа либо витаминов, то результатом этого становится уменьшение размеров образующихся эритроцитов. Это приводит к развитию такого патологического состояния, как анизоцитоз. Часто именно не поступление в организм достаточного количества витамина А провоцирует изменение размеров эритроцитов, то есть развивается анизоцитоз.
Нередко причиной развития анизоцитоза становится прогрессирование в организме человека онкологических заболеваний, которые сопровождаются появлением метастаз в головном мозге.
Медицинская практика показывает, что иногда анизоцитоз появляется после проведения переливания крови, не прошедшей проверку на это явление. В такой ситуации происходит постепенное замещение больных клеток крови здоровыми, и патология отступает.
Анизоцитоз эритроцитов удается диагностировать по анализу крови. Кроме этого, существует ряд определенных симптомов, появление которых может сигнализировать о развитии заболевания:
- человек постоянно ощущает упадок сил и не способен выполнять длительную работу
- без каких-либо причин учащается сердцебиение, причем такое патологическое состояние развивается даже в состоянии покоя
- периодически появляется одышка
- ногти, кожа и глазные яблоки становятся бледными
При возникновении у человека таких симптомов необходимо как можно скорее обратиться за помощью к специалисту.
Разновидности патологии
Изменение эритроцитов в анализе крови может свидетельствовать о развития анемии
Анизоцитоз может протекать в различных формах в зависимости от того, какие кровяные клетки видоизменились и в какой степени. Такое нарушение может протекать в организме человека в виде следующих состояний:
- макроцитоз
- микроцитоз
- смешанный анизоцитоз
Кроме этого, при общем исследовании крови обращают внимание на показатель анизоцитоза эритроцитов:
- незначительное нарушение, при котором диагностируется менее 25% видоизмененных эритроцитов
- умеренная степень разрушения характеризуется наличием измененных клеток в пределах 25-50%
- при выраженной степени патологии уровень патологических красных кровяных телец достигает 50-75%
- при резко выраженной степени все красные кровяные тельца имеют неправильный размер и форму
Часто анизоцитоз сигнализирует о прогрессировании в организме человека такой патологии, как анемия. Обычно такой недуг развивается при недостаточном поступлении в организм витамина В12, железа и других элементов. Иногда диагностируется легкая форма патологии, которая не сопровождается изменением значительного количества клеток.
Диагностика недуга и лечение
Для диагностики анизоцитоза необходимо сдать капиллярную кровь из пальца
Кровь на анизоцитоз исследуется пир проведении общего анализа крови. Забор материала для исследования проводится из пальца в утреннее время и обязательно натощак. Специалисты могут вручную определить степень анизоцитоза, но чаще всего для этих целей используются современные гематологические анализаторы.
В некоторых случаях при выявлении анизоцитоза требуется проведение более тщательного исследования — составление кривой распределения Прайса-Джонсона, на которой удается увидеть процентное соотношение всех видов красных кровяных телец. При диагностировании такого патологического состояния как макроциоз, проводится дополнительное исследование на содержание в крови фолиевой кислоты.
Изменить количественные показатели анизоцитоза удается лишь в том случае, если избавиться от причины, которая вызвала его развитие. В некоторых случаях для восстановления нормального баланса эритроцитов требуется проведение оперативного вмешательства.
Для устранения анизоцитоза требуется лечение той патологии, в результате которой он появился.
Благодаря достижениям современных медицинских технологий сегодня можно точно выявить причину развития анизоцитоза при общем исследовании крови. В том случае, если при изучении показателей проведенного анализа пациенту ставится диагноз анизоцитоз эритроцитов, то это свидетельствует о развитии железодефицитной анемии. При такой патологии необходимо пересмотреть свою систему питания и начать принимать препараты, которые способствуют повышению уровня гемоглобина. Обычно пациент начинает принимать лекарства, с помощью которых удается избавиться от дефицита железа.
Больше информации о железодефецитной анемии можно узнать из видео:
Читайте: Характеристика, расшифровка и норма rdw в анализе крови
В том случае, если у больного диагностирована анемия легкой степени и уровень гемоглобина находится в пределах 100-105, то лечение предполагает соблюдение специальной диеты. Употребление в пищу продуктов с повышенным содержанием железа помогает повысить уровень гемоглобина. При легкой степени анемии специалисты рекомендуют пациенту употреблять:
- красное мясо
- печень
- гречневую крупу
При выявлении у пациента тяжелой степени анемии проводится медикаментозная терапия. В том случае, если причиной развития заболевания стало образование в организме опухоли злокачественного характера, то прежде всего необходимо устранить ее. В такой ситуации больному показано проведение химиотерапии либо хирургического вмешательства. Нередко анизоцитоз приобретает кратковременный характер течения и в таком случае необходимо занять тактику выжидания.
Анизоцитоз у беременных и детей
В период беременности и лактации нередко у женщин диагностируется умеренный анизоцитоз эритроцитов. Такое патологическое состояние легко поддается коррекции с помощью диеты, специальных лекарств и витаминов.
Часто у будущих мамочек выявляется железодефицитная анемия и повышается содержание микроцитов. В такой ситуации основное причиной развития патологии становится дисбаланс железа, который спровоцирован внутриутробным развитием ребенка. В период беременности следует тщательно следить за показателями анализа крови, и при любых отклонениях необходимо предпринять меря по их восстановлению.
При игнорировании такого фактора возможно развитие следующих осложнений:
- гипоксия развивающегося плода
- угроза преждевременных родов
- аномалии развития плода
В том случае, если выявляется анизоцитоз при планировании беременности, то при его сочетании с пойкилоцитозом противопоказано проведение ЭКО.
Развитие различных видов анизоцитоза нередко наблюдается у новорожденных и детей старшего возраста. Обычно после перенесенного инфекционной патологии при проведении общего исследования крови у ребенка диагностируется превышение микроцитов.
Выраженный макроцитоз — это нормальное физиологическое явление у новорожденных, и обычно диагностируется у них в первые недели жизни.
Обычно такое состояние самостоятельно проходит без какого-либо лечения ко второму месяцу жизни. Выявление анизоцитоза различных форм в детском возрасте может быть опасным сигналом развития в организме:
- синдрома Кули
- нейробластомы
В такой ситуации не стоит заниматься самолечением и обязательно посетить специалиста. Важно помнить о том, что даже легкая степень анемии может являться признаком сложных патологий, прогрессирующих в организме человека. Анизоцитоз не является самостоятельным заболеванием, а всего лишь свидетельствует о течении в организме патологических процессов.
Анизоцитоз в общем анализе крови понижен
Мерой различия красных клеток крови по размеру (ширине распределения по объему) является показатель, измеряемый автоматическими гематологическими системами и обозначаемый RDW.
Оглавление:
Это и есть анизоцитоз эритроцитов (Er). Подобную задачу определения анизоцитоза в общем анализе крови решала (да и теперь иной раз решает, если в этом есть необходимость) кривая Прайс-Джонса, графическое вычерчивание которой представляет собой процесс трудозатратный и утомительный.
Лабораторная служба сейчас почти отошла от использования в качестве метода кривой Прайс-Джонса. Визуальная оценка степени анизоцидоза при морфологическом исследовании мазка (просмотр препарата под микроскопом) нередко сопровождается множеством ошибок, чего, в общем-то, никогда не замечается за аппаратами для измерения эритроцитарных и тромбоцитарных индексов – анализаторы практически не ошибаются, если они правильно откалиброваны. Анизоцитоз приборы улавливают намного эффективнее, к тому же, позволяют избавиться от артефактов визуального исследования.
Физиологические нормы красных клеток крови
Так уж повелось, что все (и медики, и пациенты) называют эритроциты – клетками, хотя на самом деле это не совсем так, однако такое определение укоренилось, поэтому нет смысла отступать от общепринятых негласных правил и что-то менять. Клетки и клетки…
Кроме этого, прежде чем приступить к описанию данного эритроцитарного индекса, хочется ответить на один из часто задаваемых вопросов — с чем связан диагноз анизоцитоз у детей? Конечно, можно понять беспокойство родителей, обнаруживших незнакомое слово в результатах гемограммы своего малыша, однако этот медицинский термин по своей сути не имеет различий по отношению к анализу крови ребенка или взрослого человека. Хотя, правда, у детей чаще отмечается анизоцитоз с преобладанием микроцитов, что указывает на развитие железодефицитной анемии — она наиболее характерна для детского и подросткового возраста. В остальном – все аналогично, поэтому в описании показателя не будет сделан акцент ни на детский возраст, ни на взрослое состояние.
Итак, эритроциты — форменные элементы крови, безъядерные кровяные тельца, имеющие круглые или слегка овальные очертания и форму двояковогнутых дисков. Эта форма необходима эритроцитам для того, чтобы они могли в значительной степени увеличивать площадь поверхности для осуществления полноценного газообмена.
Нормальные значения диаметра эритроцитов не покидают границ 7 – 8 микрон, а физиологический диапазон колебаний этого показателя красных клеток составляет 5,5 – 9,5 микрон (графическое выражение – кривая Прайс-Джонса). Средние значения объема эритроцитов располагаются в пределах 80 – 100 фемтолитров (или кубических микронов) – это норма MCV. Клетки, имеющие такие параметры, называются нормоцитами и подавляющее большинство красных кровяных телец должны принадлежать именно данной категории.
Расчет эритроцитарных индексов, входящих в общий анализ крови (гемограмма): МСН (среднее содержание красного пигмента – гемоглобина, Hb), МСНС (средняя концентрация Hb в красной клетке крови), MCV (средний объем эритроцитов), а также показателя гетерогенности (разнородности) красных кровяных телец по объему (степень анизоцитоза эритроцитов — RDW) в настоящее время возложен на гематологические автоматические анализаторы. Норма RDW (или анизоцитоза эритроцитов) составляет от 11,5% до 14,5%.
Причиной анизоцитоза в общем анализе крови могут быть дефицитные состояния (недостаток витамина В12, фолиевой кислоты, железа), злокачественный опухолевый процесс, осложнения после переливаний крови (иммунные реакции), нарушение кроветворения в костном мозге, хроническая инфекция, сердечная патология (развитие ИБС).
Анизоцитоз эритроцитов
Между тем, при различных анемических состояниях, в зависимости от типа патологии, и диаметр, и объем кровяных телец может заметно варьировать в ту или иную сторону – популяция эритроцитов становится разнородной (наличие подобного видоизменения клеток позволяет проводить дифференциальную диагностику анемий). Таким образом, в крови, помимо нормоцитов, появляются аномальные эритроциты разных объемов (гетерогенность популяции красных клеток):
- Неестественно увеличенные, огромные, «раздутые» – мегалобласты (диаметр этих клеток превышает 9,5 мкм);
- Чуть поменьше мегалобластов, но больше нормоцитов – макроциты;
- Маленькие форменные элементы (клеточки-лилипуты) – микроциты.
Большинство гематологических анализирующих приборов, предназначенных для исследования основных характеристик клеточного состава периферической крови, рассчитывают степень анизоцитоза эритроцитов по формуле в качестве коэффициента вариации среднего объема красных кровяных телец (MCV):
SD – стандартное отклонение объема Er, MCV – средний объем Er.
С приходом в лабораторную службу гематологических анализирующих систем окончательно стало ясно, что состояний, когда бы показатель оказался пониженным, просто-напросто, не существует. Ну, а если он все-таки понижен – значит, что-то неладное с автоматом-анализатором, который производил расчет, поэтому персоналу придется заняться калибровкой, чтобы получить правильные результаты анизоцитоза в общем анализе крови, а пациенту — еще раз посетить лабораторию, чтобы не волноваться попусту.
Глаза врача — незаменимы
Любой самый «умный» анализатор, между тем, не отменяет работу врачей лабораторной диагностики, в функциональные обязанности которых входит проведение гематологических исследований. Помещая пробу в аппарат, лаборант параллельно готовит (красит и сушит) мазок, предназначенный для визуального просмотра (микроскоп + глаза врача) и определения степени анизоцитоза эритроцитов.
анизоцитоз в крови, эритроциты — разных размеров
Если в препарате все поле покрыто клетками приблизительно одинаковых объемов (нормоцитами), то об анизоцитозе никаких отметок в бланке гемограммы не делают. Отражают данный показатель в общем анализе крови, если аномальные эритроциты претендуют на широкое распространение в мазке. Понятно, если врач видит маленькие клетки, он указывает на анизоцитоз с преобладанием микроцитов, если большие – отмечает макроцитоз.
Однако, наряду с микро- и макроцитозом по отдельности, существует еще один вариант – смешанный анизоцитоз. Об анизоцитозе смешанного типа говорят, когда в препарате до 50% поля занимают аномальные клетки и не понять, какие из них превалируют: мегалобласты, макроциты (можно подозревать дефицит витамина В12, недостаток фолиевой кислоты или пернициозную анемию), либо мазок преимущественно «заселяют» лилипуты – микроциты (тогда последует предположение о развитии железодефицитного состояния — ЖДА). В подобных случаях врач сообщает об анизоцитозе смешанного типа отметкой в бланке анализа и тем самым заостряет внимание лечащего врача, который, в свою очередь, назначит дополнительное обследование пациенту.
Следует заметить, что подобные обстоятельства иной раз заставляют врача лабораторной диагностики возвращаться к использованию графического выражения данных параметров (или кривой Прайс-Джонса).
Кроме этого, не зря ведь употребляется термин «степень анизоцитоза эритроцитов», его действительно различают по степеням, выделяя:
- Незначительный анизоцитоз – аномальные клетки занимают до 1/4 части (до 25%) в мазке крови, результат может выражаться одним плюсом (+);
- Умеренный – аномальных клеток в пределах половины от всего сообщества, попавшего в мазок (до 50%), или результат: ++;
- Выраженный – 3/4 от всех эритроцитов берут на себя клетки с измененным объемом (до 75%) или результат: +++;
- Высокая (острая) степень анизоцитоза — аномальные клетки практически занимают все поле (до 100%), результат может быть выражен 4-мя плюсами (++++).
Вместе с тем, не глядя на сложность ситуации, не стоит пытаться сопоставлять кривую Прайс-Джонса, коль ее все равно пришлось «рисовать», и гистограмму, выданную анализатором, ведь первая отражает величину распределения по диаметру, а вторая – по объему, поэтому два метода имеют ряд отличий и особенностей.
Анизоцитоз эритроцитов и диагностика анемий
Оценка размеров эритроцитов и вычисление эритроцитарных индексов играет не последнюю роль в диагностике анемий, поскольку отражает состояние костномозгового кроветворения (эритропоэза). Показатель степени анизоцитоза дает возможность выделить следующие варианты анемического состояния, то есть, обозначить типы анемий:
- Сдвиг в сторону макроцитов указывает на омоложение красных кровяных телец и их неполное созревание, что обычно связано с недостатком витамина В12, фолиевой кислоты или прочих гемопоэтических факторов, участвующих в кроветворении. В данном случае можно говорить о мегалобластной или макроцитарной анемии;
- Большое количество маленьких клеток – микроцитов (или анизоцитоз с преобладанием микроцитов) может свидетельствовать о направленности эритропоэза в сторону микронормобластов, что происходит при недостаточном содержании в организме железа (железодефицитная анемия) или прочих специфических компонентов – микроцитарная анемия;
- В отношении нормы – все не так однозначно. Нормальный уровень анизоцитоза отнюдь не означает отсутствие патологии, что, к примеру, происходит в случае апластической анемии или анемических состояний, связанных с хронической патологией.
Кроме этого, для получения полноты картины красной крови анизоцитоз эритроцитов, выданный анализатором в цифровом выражении, сопоставляют с данными гистограммы, отражающей частоту встречаемости клеток разных объемов.
Анизоцитоз тромбоцитов
Возможности современных гематологических автоматических систем, наряду с определением различных параметров крови (количество красных и белых клеток, уровень гемоглобина и гематокрит, эритроцитарные индексы и лейкоцитарная формула), позволяют вести подсчет кровяных пластинок – тромбоцитов (которые при обработке общего анализа крови вручную требуют отдельной окраски), а также тромбоцитарных индексов и показателя анизоцитоза тромбоцитов – PDW.
примеры тромбоцитарных гистограмм: норма, тромбоцитопения, гипертромбоцитоз (наличие макротромбоцитов)
В автоматическом анализаторе для подсчета тромбоцитов используют один с эритроцитами канал, поэтому данные приборы снабжены специальной системой электронных дискриминаторов, которые дифференцируют:
- Макротромбоциты;
- Микроэритроциты;
- Шизоциты (фрагменты красных клеток крови);
- Клеточный дебрис (фрагменты цитоплазмы белых клеток – лейкоцитов).
PDW – показатель анизоцитоза тромбоцитов, норма которого составляет от 14 до 20%, вместе с другими тромбоцитарными индексами (РСТ, P-LCP) не имеет особого диагностического значения. Наибольший объем информации в подобных случаях можно ожидать от гистограммы распределения тромбоцитов.
Изменения показателя анизоцитоза тромбоцитов в сторону увеличения характерны для миелопролиферативных процессов, в сторону уменьшения – для отдельных форм лейкозов, апластической анемии, ДВС-синдрома, тяжелых поражений печени и некоторых других состояний.
Источник: https://sosudinfo.ru/krov/anizocitoz/
Что такое анизоцитоз в крови человека
В человеческом организме кровь играет важную роль, ее регулярная проверка может показать наличие заболеваний. Узнать о развитии патологии можно, сдав общий анализ. При рассмотрении результата специалист изучает размер клеток. Если он отличается от нормы – диагностируется повышенное содержание измененных тромбоцитов или эритроцитов.
Анизоцитоз в общем анализе крови
Исследование предполагает изучение размера, цвета, формы клеток крови. Эритроциты – это кровяные тельца, которые отвечают за обогащение кислородом. Тромбоциты укрепляют сосуды, если они были повреждены. Отслеживание их показателей обязательно для каждого, ведь многие заболевания отражаются на результатах анализа крови. Диагноз anisocytosis характеризуется высоким содержанием клеток измененного размера.
Эта проблема может касаться эритроцитов и тромбоцитов, но по статистике преобладают эритроциты. При диагностировании повышенного количества измененных кровяных частиц по размеру ставится соответствующий диагноз. Обозначение анизоцитоза в общем анализе крови следующее: RDW – это ширина распределения эритроцитов по объему. В медицине RDW измеряется в процентах или в фемтолитрах. Патология формы кровяных клеток называется пойкилоцитозом.
Обратите внимание!
— Грибок вас больше не побеспокоит! Елена Малышева рассказывает подробно.
— Елена Малышева- Как похудеть ничего не делая!
Анизоцитоз эритроцитов
В организме здорового человека норма эритроцитов составляет 70%, микро- и макроцитов – 11,5-14,5% (илиfl). У ребенка до 6 месяцев показатель выше – от 15% до 18,8%. При беременности он может увеличиваться. Если результат превышает или не достигает нормы, это означает, что происходит развитие патологического процесса. Также бывает микроцитоз – уменьшение допустимого диаметра. Различают следующие показатели диаметра клеток:
- нормоциты достигают 7-8 мкм (анизоцитоза эритроцитов не обнаружено);
- макроциты – выше 8 мкм;
- мегалоциты – выше 12 мкм.
Эта патология может быть вызвана недостаточным количеством в организме витаминов группы А и В, онкологическими болезнями с метастазами в костный мозг. Не стоит исключать и заболевания печени, нарушения функции щитовидной железы. Еще возможная причина – переливание донорской крови. Чтобы вовремя предупредить болезнь, необходимо регулярно отслеживать состав и показатели крови.
Показатель анизоцитоза эритроцитов выше нормы
Увеличенный результат анализа является часто встречающимся у пациентов с дефицитом железа или витаминов. Если проверка крови выявила показатель анизоцитоза эритроцитов выше нормы, это сигнал о том, что развивается патология. Зависимо от стадии, врач поставит диагноз и назначит курс лечения. Часто причиной таких изменений является анемия любого типа.
Заболевание имеет классификацию по степени интенсивности. Их всего 4 и распределяются они по системе плюсов:
- Первая степень характеризуется незначительным повышением, когда макроциты и микроциты заполняют 30-50% (+).
- Вторая – умеренная, 50-70% (++).
- Третья – выраженная, более 70% (+++).
- Четвертая – резко выраженная, почти все красные тельца имеют патологический размер (++++).
Показатель анизоцитоза эритроцитов ниже нормы
Крайне редко индекс RDW понижен, в таких случаях рекомендуется сдать анализ крови заново. Если показатель анизоцитоза эритроцитов ниже нормы, а другие значительные изменения отсутствуют, такой анализ принято считать удовлетворительным и пересдавать не требуется. Иногда при наличии определенных заболеваний результат RDW не изменяется. Пониженный результат не имеет никакой ценности для диагностики.
Анизоцитоз смешанного типа
Данный вид патологии характеризуется пониженным уровнем общего содержания микроцитов (микроанизоцитоз) и макроцитов. Чтобы правильно определить процентное соотношение, во время исследования используется метод Прайса-Джонса. Смешанный анизоцитоз предполагает преобладание макроцитов. Источник этого изменения – дефицит витаминов А, В12, вследствие чего развивается анемия. Еще стоит обратить внимание на состояние печени. Если в большем количестве обнаружен макроцитоз – это говорит о недостатке железа.
Анизоцитоз тромбоцитов
Защитная функция, предотвращающая острые кровопотери, выполняется кровяными частицами под названием тромбоциты. Они очень важны для человеческого организма и отвечают за способность свертывания крови. В анализе нормальный показатель количества частиц измененных размеров должен составлять от 14 до 18%. При анизоцитозе тромбоцитов цифры отличаются. При исследовании в анализе индекс тромбоцитов обозначается как PDW.
Эта патология имеет свои истоки, объясняется наличием различных заболеваний, так как она – лишь сопутствующий им симптом. Пациент ощущает физиологическое изменение. Его самочувствие ухудшается. Изменения размеров клеток тромбоцитов провоцируются при геморрое (при трещинах заднего прохода), при обильной менструации. Еще возможные причины:
- миелонеопластические процессы;
- лейкемия;
- печеночная недостаточность;
- вирусное поражение;
- лучевая болезнь;
- апластическая анемия;
- недостаток биологически активных веществ;
- ДВС-синдром.
Анизоцитоз – причины
Любое изменение крови имеет под собой основания, которые необходимо выяснять, чтобы найти корень проблемы. Причины анизоцитоза имеют разный характер, зачастую они следующие:
- нерациональное питание, как результат – нехватка железа, витаминов В12 (преобладание мегакариоцитов), А, которые отвечают за создание красных форменных кровяных телец;
- онкология;
- переливание крови – материал донора должен проверяться на наличие этого заболевания, ведь оно передается другому человеку;
- миелодиспластический синдром – провоцирует изменение размеров клеток крови.
Поскольку данное заболевание является сопутствующим синдромом многих болезней, по результату анализа могут подтверждаться некоторые патологии. Например, пациенты, страдающие железодефицитной анемией, знают не понаслышке, что такое анизоцитоз. Еще диаметр кровяных частиц в мазке меняется при дивертикулезе, при эндокринных болезнях, как побочный эффект при приеме гормональных препаратов, при нарушении всасывания витаминов группы В, при язвенной болезни. Зная все про анизоцитоз – что это такое, и понимая его причины, можно избежать развития многих опасных болезней.
Анизоцитоз – лечение
Чтобы эффективно избавиться от проблемы, необходимо сначала провести ряд исследований и выявить первичную болезнь, повлекшую за собой изменения в составе крови. При лечении анизоцитоза (включая смешанный тип) учитывается наличие железодефицитной анемии: если она подтверждается, врач определяет уже ее причину (хронические кровотечения, обильные менструации). Если был найден дефицит железа или витаминов, то назначаются препараты и основное условие – специальная диета, которая восполнит недостающие элементы и поможет понизить количество измененных клеток.
Видео
Информация представленная в статье носит ознакомительный характер. Материалы статьи не призывают к самостоятельному лечению. Только квалифицированный врач может поставить диагноз и дать рекомендации по лечению исходя из индивидуальных особенностей конкретного пациента.
Источник: https://sovets.net/13824-anizocitoz-chto-eto-takoe.html
Анизоцитоз эритроцитов в анализе крови (индекс RDW)
Норма RDW
Классификация анизоцитоза
- первая (незначительный анизоцитоз) – микроциты и макроциты составляют%;
- вторая (умеренный) –%;
- третья (выраженный) – выше 70 %;
- четвертая (резко выраженный) – практически все красные клетки имеют размер, отличный от нормального значения.
- микроцитоз – увеличение числа малых клеток;
- макроцитоз – увеличение числа макроцитов;
- смешанный – увеличение числа и малых, и больших клеток.
- анемии железодефицитной;
- при отравлении свинцом;
- талассемии;
- сидеробластной анемии;
- при анемии, связанной с хроническими кровотечениями;
- при некоторых злокачественных заболеваниях.
При анизоцитозе в крови присутствуют эритроциты как малых, так и больших размеров
- нарушением синтеза ДНК, который может быть связан с приемом некоторых медикаментов, миелодисплазией, эритролейкозом, дефицитом фолиевой кислоты и кобаламина.
- патологией липидов мембраны эритроцитов при заболеваниях печени, алкоголизме, гипотериозе, после удаления селезенки.
Причины повышения и понижения RDW
- Железодефицитная анемия.
- Гемолитическая анемия.
- Мегалобластная анемия (дефицит витамина B12 и фолиевой кислоты).
- Хронические болезни печени.
- Метастазы в печень.
- Переливания крови.
- Миелодиспластический синдром.
- Алкогольная зависимость.
- малокровие, сопровождающее хронические заболевания;
- β-талассемия;
- сфероцитоз;
- острые апластические и геморрагические анемии;
- серповидно-клеточная анемия.
Анализ на RDW
Заключение
Гость — 20 декабря,:58
Что означает пояснение лаборанта в показателе эритроциты — анизоцитоз ++ «складываются в ручейки и монетные столбики»?
Лазарева — 5 декабря,:22
В анализе крови гемоглобин 103, анизацитоз эритроцитов ,палочки 11, 2 базофила, 2 эозинофила.
Источник: https://serdec.ru/krov/anizocitoz-eritrocitov-analize-krovi-indeks-rdw
Анизоцитоз эритроцитов смешанного, умеренного и выраженного типа
Анизоцитоз в общем анализе крови – это термин, употребляющийся при лабораторном исследовании и описывающий отклонение от нормы количества форменных элементов крови, которые, вследствие заболевания или по каким-то другим факторам, претерпели изменения в своих размерах.
При любом подозрении на анемию выполняется анализ крови с обсчётом индекса RDW.
Эритроциты нормального размера называются нормоцитами. Соотношение нормоцитов и эритроцитов с другими размерами должно быть в пределах 70 к 30.
Размеры нормоцитов колеблются в границах 6,8-7,5 микрон. Нормального размера эритроциты у детей зависят от текущего месяца или года жизни – 7,0- 8,12 мкм.
Эти цифры не приведены к «единому стандарту», поэтому в различных источниках можно встретить изменение величины ниже и выше — от 6 до 9 мкм. Анизоцитоз эритроцитов возникает тогда, когда количество красных кровяных клеток с ненормальными размерами повышено — выше допустимого 30% порога.
Причины возникновения
Главными виновниками появлениями анизоцитоза в анализе крови являются различные виды анемий, причем основная масса случаев приходится на железодефицитные синдромы. К другим причинам возникновения такого состояния относятся:
- нарушение синтеза ДНК, гипотиреоз, лейкоз, хроническая интоксикация печени и цирроз, неполноценное питание, беременность;
- генетические изменения в полипотентных стволовых клетках, которые вызываются целым рядом неблагоприятных факторов и патологий в старшей возрастной группе (после 60 лет);
- рак красного костного мозга и онкологические болезни, метастазирующие в костный мозг – рак лёгких, онко-опухоли молочной, предстательной или щитовидной желёз, карциномы ЖКТ или почек, лимфомы, меланомы, саркомы;
- массивные кровопотери, переливание крови, отравление свинцом, сидеробластная анемия, беременность, кормление грудью.
Разновидности
Эритроциты, которые отличны своими размерами от нормы, получили названия:
- микроциты – менее 6 мкм;
- шизоциты – обломки эритроцитов, размерами 2-3 мкм;
- микросфероциты – красные кровяные клетки шарообразной формы и диаметром 4-6 мкм;
- макроциты – размер повышен, более 8 мкм;
- мегалоциты – более 12 мкм.
В зависимости от того, какой размер кровяных телец присутствует в плазме крови в увеличенном размере (выше 15%) различают следующие разновидности анизоцитоза эритроцитов:
- Микроанизоцитоз. Основной причиной повышения уровня микроцитов считается нарушение синтеза гемоглобина. Такое изменение часто сопровождает железодефицитные анемии, талассемию, гемоглобинопатии, некоторые хронические инфекционные заболевания. Микроцитоз может сам стать признаком другой патологии и побудить к прохождению дополнительных анализов – например, на наличие гипохромной анемии.
- Шизоцитоз. За повышение уровня содержания в крови обломков эритроцитов – шизоцитов, несут ответственность следующие заболевания: васкулиты, микроангиопатическая гемолитическая анемия, миелодиспластический синдром, гломерулонефрит, уремия; маршевая гемоглобинурия и причины, вызывающие ДВС-синдром.
- Микросфероцитоз. Синдром, который в 75 % случаев передаётся по наследству. Наличие аномального количества микросфероцитов вызывается генной мутацией или нарушением выработки веществ, которые приводят к патологии развития плазматической мембраны эритроцита, вызывающее уменьшение его размера. У ребёнка микросфероцитоз возникает по единственной причине – при болезни Минковского-Шоффара.
- Макроцитоз. Такое состояние возникают из-за специфических, как правило, наследственных, изменений в кроветворной системе – макроцитов производится больше нормы и нарушается временной баланс между их воспроизводством и гибелью. Макроцитоз характерен для В12-дефицитной анемии, наследственной несфероцитарной гемолитической анемии, врождённой гемолитической анемии Дайка-Янга, может возникнуть при злокачественных новообразованиях, некоторых поражениях печени и при понижении функций щитовидной железы.
- Смешанный анизоцитоз. Анизоцитоз смешанного типа, характеризуется аномальным количеством как больших, так и малых форм эритроцитов. Если в анализе преобладают макроциты, то возможно наличие у больного пернициозной или В12- дефицитной анемии. Если же больше микроцитов – возможна гипохромия и железодефицитная анемия.
Степени и симптомы
От продолжительности и тяжести течения заболевания, которое вызвало дисбаланс в соотношении между микроцитами, макроцитами и нормоцитами, зависит показатель анизоцитоза эритроцитов. В зависимости от уровня содержания (%) видоизменённых эритроцитов, анизоцитоз делиться на 4 степени тяжести:
- Незначительная – ниже 30;
- Умеренная – от 30 до 50;
- Выраженная – от 50 до 70;
- Резко выраженная – выше 70 %.
Даже когда анизоцитоз понижен (показатели менее 30%), особенно у ребёнка, необходимо провести дополнительные исследования изменений, произошедших в организме, для того, чтобы исключить другие серьёзные заболевания.
Для всех анизоцитозов характерны следующие признаки, величина проявления которых зависит от продолжительности течения основного заболевания и возраста больного:
- пониженная работоспособность, слабость, быстрая утомляемость;
- понижение концентрации внимания;
- сухость, покраснение и пощипывание языка, извращение вкуса, хейлит – заеды;
- тошнота, позывы к рвоте, нарушение глотания – синдром Пламмера-Винсона;
- сухость кожи, ломкость волос и ногтей;
- нарушение чувствительности кожи;
- побледнение губ, кожных покровов и посинение ногтевых пластинок;
- жжение и зуд в области вульвы, снижение либидо;
- учащение сердцебиения, увеличение сердечного толчка;
- одышка, головная боль, головокружения, обмороки;
- шум в ушах, головная боль, головокружения, обмороки;
- изменения в режиме сна;
- боли в брюшной полости, увеличение селезёнки и печени (иногда).
Анизоцитоз у беременных
Во время беременности или в период кормления грудью достаточно часто возникают состояния умеренного анизоцитоза эритроцитов, которые легко корректируются диетой, витаминными комплексами и приёмом лекарственных препаратов.
В большинстве случаев, у беременных возникает железодефицитная анемия и повышенный уровень микроцитов. Причиной становится нехватка железа, вызванная развитием плода.
Необходимо тщательно следить за показателями анализа крови, и в случае отклонения от нормы, немедленно выполнять действия для их восстановления, поскольку игнорирование такого фактора может привести к гипоксии плода, отёчности и его аномальному развитию, угрозе выкидыша или преждевременным родам.
Если анизоцитоз диагностируется при планировании беременности, то в случае сочетания его с пойкилоцитозом (изменение формы эритроцитов) он становится прямым противопоказанием для проведения ЭКО и требует проведения соответствующих лечебных мероприятий.
«Детский» анизоцитоз
Различные виды анизоцитоза возможны у новорожденных, детей грудного и более старшего возраста. Микроциты выше нормы присутствуют в анализе у ребёнка после любого инфекционного заболевания.
Выраженный макроцитоз считается нормой, и как физиологическое явление наблюдается у новорождённых, особенно в течение первых двух недель жизни. Физиологический макроцитоз новорождённых проходит самостоятельно ко второму месяцу жизни.
Диагностика анизоцитоза разных форм у детей может быть и более грозными звоночками к наличию нейробластомы, гипохромной анемии, хлороза или синдрома Кули.
Диагностика и лечение
Анизоцитоз выявляется при общем анализе крови и в некоторых случаях требует более тщательного исследования – составления кривой распределения Прайса-Джонсона, отображающей процентное соотношение всех видов эритроцитов. После выполнения анализа, результаты вносятся в графы с индексами RDW-CV и RDW-SD.
При макроцитозе необходимо выполнить дополнительный анализ на содержание в крови фолиевой кислоты, а для уточнения диагноза «болезнь Минковского-Шоффара» – стернальную пункцию, пробу на специфические антитела и ряд анализов, которые позволят исключить гепатит.
Изменить количественные показатели анизоцитоза, можно только вылечив причину его возникновения. Иногда для восстановления баланса эритроцитов, приходиться прибегать и к оперативному хирургическому вмешательству.
Например, частый метод лечения микросфероцитоза на фоне выраженной гипербилирубинемии – удаление селезёнки, которое позволяет нормализовать общее состояние и поднять уровень гемоглобина. Однако, у детей в возрасте до 10 лет удаление производиться только в крайних случаях, когда все другие методы лечения исчерпаны.
При выявлении анизоцитоза в анализе крови, врач, ещё до окончательного утверждения диагноза, предложит срочно поменять систему питания и пересмотреть пищевой рацион.
Если серьёзные заболевания отсутствуют, то сбалансированное питание, соблюдение здорового образа жизни, достаточное количество часов отдыха и сна, помогут избавиться от анизоцитоза и восстановить норму, не прибегая к специальным лекарственным препаратам.
Источник: https://redkrov.ru/patologii/anizocitoz-v-analize-krovi.html
Разбираемся, что такое анизоцитоз эритроцитов?
Внутренняя среда организма представлена кровью и лимфой. Кровь состоит из форменных клеток (эритроциты, тромбоциты, лейкоциты), находящихся в плазме – жидкой среде крови.
К характеристикам крови относится не только количественный показатель содержания форменных клеток в плазме, но и размер самих клеток, а также занимаемый ими объем.
Анизоцитоз
Эритроциты – красные кровяные тельца, выполняющие функцию транспортировки: доставляют молекулы кислорода от легких к тканям, органам, и углекислый газ в обратном направлении.
Показатель нормы размера эритроцитов составляет 7 -7.5 микрометров в диаметре, такие клетки называют нормоцитами. Диаметр меньше 6,9 мкм характерен для микроцитов. Клетки размером, превышающим 8 мкм, называются макроцитами, свыше 12 мкм – мегалоцитами.
В нормальной среде крови нормоциты составляет 70% от общего объема эритроцитов, микроциты и макроциты – 15%.
Изменение размеров красных клеток и как следствие, отклонение в соотношении объема кровяных тел, называется анизоцитоз эритроцитов.
В зависимости от процентного соотношения разных форм эритроцитов выделяют анизоцитоз:
- 1 степени (содержаниемикро и макроцитов составляет выше 30% , но ниже 50% от общего объема эритроцитов);
- 2 степени (выше 50% , ниже 70%);
- 3 степени (выше 70%);
- 4 степени (полное замещение нормоцитов измененными клетками).
- микроцитоз (повышенное содержание микроцитов);
- макроцитоз (преобладают макроциты, их уровень выше)
- смешанный тип (измененное количество, как микро, так и макроцитов).
Причины
Изменение диаметра эритроцитов может произойти в результате:
- анемии (уровень железа в организме понижен);
- приема железосодержащих препаратов на начальной стадии лечения анемии;
- нехватки витаминов А или В12;
- переливания крови;
- развития онкологических заболеваний;
- миелодиспластического синдрома (нарушение образования кровяных клеток);
- хронических инфекций, осложнений при простуде.
Анализ крови
Анизоцитоз диагностируется при сдаче общего анализа крови.
Забор крови берется из пальца пациента (у новорожденных из пятки) чаще всего утром, желательно на голодный желудок (у маленьких детей спустя 2 часа после кормления).
До проведения процедуры следует исключить физические нагрузки, эмоциональные потрясения, переохлаждение организма.
Также на показатель анализа могут повлиять прием медицинских препаратов (лекарства желательно принять за 12 часов до процедуры или после нее), беременность (наблюдается повышенное содержание мегалоцитов).
При расшифровке результатов анализа анизоцитоз обозначается аббревиатурой RDW – индекс показателя распределения эритроцитов по объему (RDW).
Индекс RDW измеряется в фемтолитрах или процентах, норма RDW:ft или 11.5% -14.5%.
Если индекс повышен или понижен, это указывает на наличие некоторых нарушений в организме, следует применить дополнительные методы обследования.
При индексе RDW значительно выше или ниже нормы (3-4 степени анизоцитоза) необходимо повторить процедуру для подтверждения диагноза.
Анизоцитоз у детей
Наличие макроцитоза у новорожденных является нормальным физиологическим показателем, который самостоятельно исчезает к двум месяцам жизни.
В связи с повышенной склонностью детей к заболеванию железодефицитной анемией, низкий уровень гемоглобина становиться наиболее частой причиной развития анизоцитоза у ребенка.
Прием железосодержащих препаратов также провоцирует изменение размера кровяных клеток, однако, по мере уравновешивания концентрации гемоглобина в крови, результаты анализа приходят в норму.
Реже причинами могут стать вирусные и бактериальные инфекции в организме.
При переливании крови причиной развития патологии может стать плохое исследование донорской крови, такое заболевание исчезает самостоятельно через некоторое время.
Более тяжелые формы анизоцитоза у детей формируются при онкозаболеваниях (метастазы в костном мозге) и миелодиспластическом синдроме.
Смешанный анизоцитоз
Для смешанного типа анизоцитоза характерен показатель измененных красных клеток, не выше 50% от общего содержания эритроцитов. Такое явление также является патологией.
Для определения процентного соотношения микро и макроцитов применяют метод исчисления – кривая Прайса- Джонса, полученную при исследовании мазка крови.
Повышенный показатель макроцитов указывает на нехватку витамина В12 в организме (пернициозная анемия).
Преобладание микроцитов, скорее всего, связано с наличием железодефицитной анемии.
Анизоцитоз тромбоцитов
Тромбоциты – кровяные клетки, выполняющие функцию свертывания крови.
При анализе крови оценивается ширина распределения тромбоцитов по общему объему крови, что указывает на их размерное соотношение.
Изменение тромбоцитов в диаметре (анизоцитоз) может быть вызвано наличием миелопролиферативных процессов, осаждением клеток, нехваткой биологически активных веществ, размер клеток меняется перед началом агрегации (склеиванием тромбоцитов).
Анизоцитоз тромбоцитов наблюдается:
- при наличии тромбоцитопении, тромбоцитопатии, гипопластического синдрома (более 15% клеток подвержено изменению);
- в результате лейкемии (рак крови), метастазов в костном мозгу;
- при лучевой болезни, анемии;
- при развитии гепатита, цирроза печени;
- в течение вирусных заболеваний;
- провоцирует прием цитостатических препаратов.
В видео речь идет об анизоцитозе тромбоцитов, рекомендуем посмотреть
Лечение и профилактика
При отсутствии тяжелых заболеваний терапия анизоцитоза сводится к устранению нехватки витамин и железа в организме, к дефициту которых могут привести большие кровопотери (травмы, обильная менструация), плохая работа ЖКТ, язвенные болезни, гормональные изменения, прием лекарственных средств.
Лечение анизоцитоза тромбоцитов связано с определением и терапией основного заболевания.
К профилактическим мерам относят:
- полноценное питание, при необходимости дополнительный прием витамин и железосодержащих препаратов;
- активный образ жизни, с прогулками на свежем воздухе;
- своевременная сдача анализов и обращение к врачу при плохом самочувствии.
Добавить комментарий Отменить ответ
При использовании данного сайта, вы подтверждаете свое согласие на использование файлов cookie в соответствии с настоящим уведомлением в отношении данного типа файлов. Если вы не согласны с тем, чтобы мы использовали данный тип файлов, то вы должны соответствующим образом установить настройки вашего браузера или не использовать сайт.
Источник: https://1pokrovi.ru/analizy-krovi/obshhij-analiz/anizocitoz-eritrocitov/chto-takoe.html
Анизоцитоз в общем анализе крови
Анизоцитоз: что это такое?
Анизоцитоз эритроцитов
Эритроциты, меньшие по диаметру (